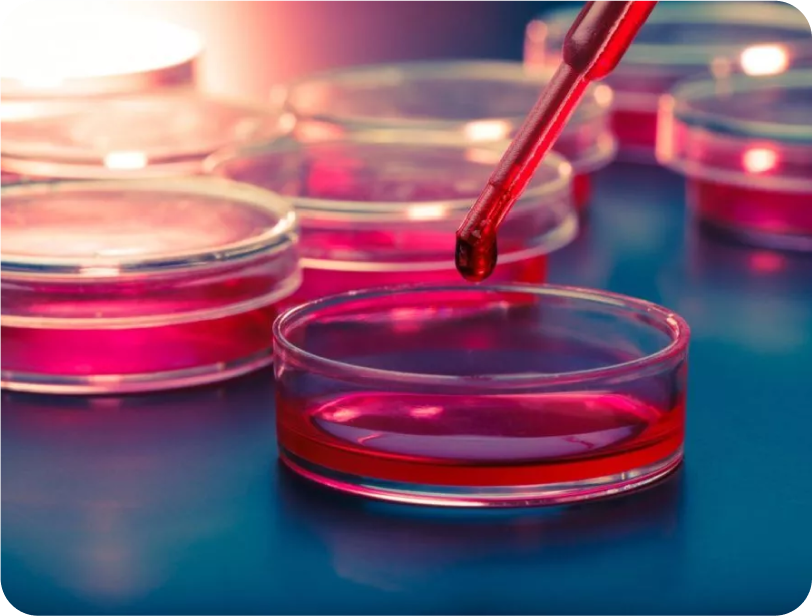

Vos cellules, leur espoir
Sauver des vies en fournissant un stockage et un don gratuits de cellules souches du sang périphérique pour traiter le cancer du sang et 75 types de troubles sanguins comme la thalassémie, l'anémie aplasique, etc.
Pour la première fois en Inde, la Fondation Kanakam change ce récit en offrant un stockage gratuit de cellules souches et des dons pour un accès mondial, malgré leurs antécédents financiers.
Une greffe de cellules souches peut être leur seul espoir. Cependant, le coût élevé du traitement et du stockage des cellules souches rend souvent cette thérapie vitale hors de portée pour beaucoup.

Au cours des dernières années, la Fondation Kanakam s'est consacrée à fournir des cellules souches sanguines vitales aux patients dans le besoin, grâce au soutien indéfectible de nos précieux partenaires. Ce parcours marquant a permis à d’innombrables personnes de recevoir les soins dont elles avaient un besoin urgent.
Dans le cadre d'une étape importante de notre mission, nous sommes fiers d'annoncer notre intention d'établir le propre centre et laboratoire de collecte de cellules souches sanguines de la Fondation Kanakam au cours de l'année 2025. Cette installation de pointe améliorera notre capacité à :
Comment vous pouvez aider